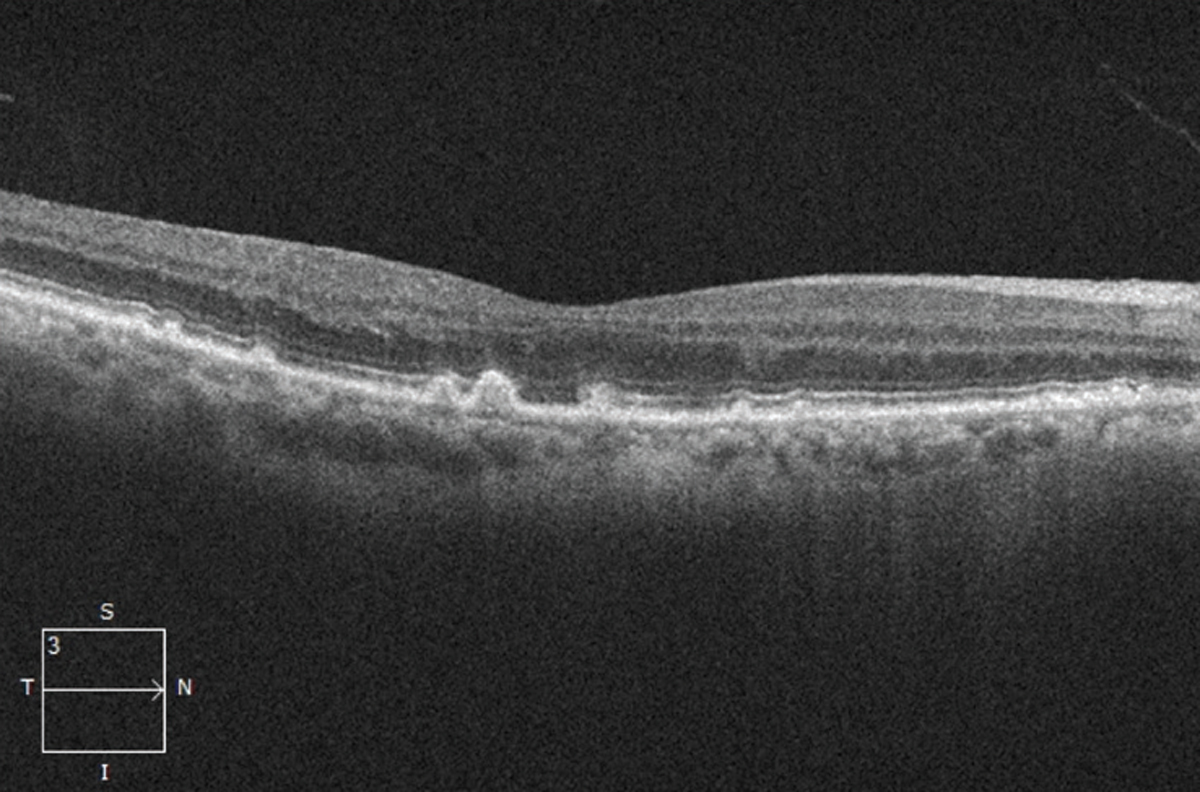
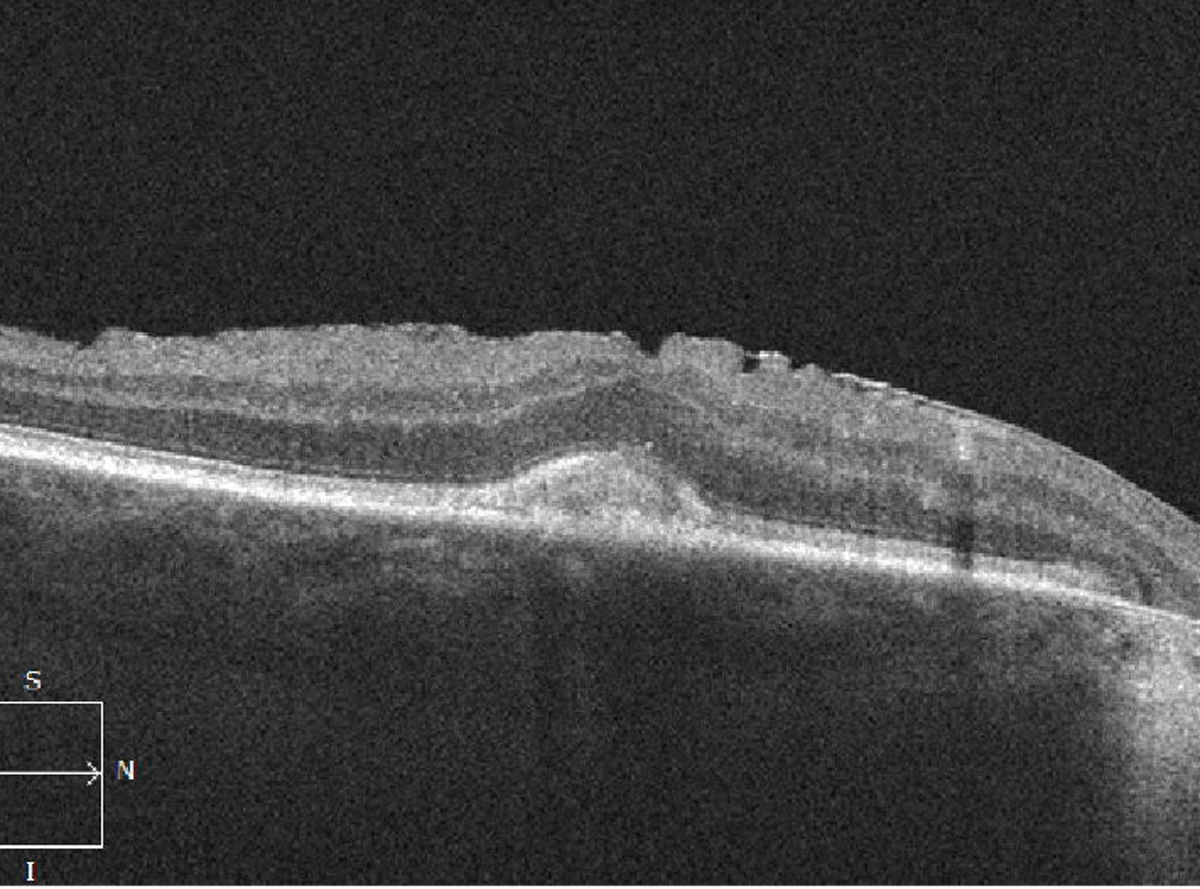

![]() |
|
Bios Dr. Grinton is a medical retina fellow at University Health Network, Toronto. Mr. Papinikolaou is a research student at the University Health Network, Toronto. Dr. Grewal is a vitreoretinal surgeon in Edmonton, Alberta. Dr. Yan and Dr. Weisbrod are assistant professors of ophthalmology at the University of Toronto. Dr. Mandelcorn is an associate professor of ophthalmology at the University of Toronto. DISCLOSURES: The authors have no relevant financial relationships to disclose. |
Age-related macular degeneration has been classically categorized as “dry” (non-neovascular or nonexudative) vs. “wet” (neovascular or exudative), but this categorization may be an oversimplification that may not encapsulate the full spectrum and complexity of the disease. Furthermore, the terms neovascular and exudative may not be fully interchangeable. Here, we’ll provide a overview of the variants of AMD and their mimickers with the purpose of guiding management of this multifaceted disease.
The presence of drusen and retinal pigment epithelium changes characterize non-neovascular or nonexudative—dry—AMD in the absence of neovascularization (Figure 1). Historically, the Age-related Eye Disease Study classified dry AMD based on examination findings of hard drusen, soft drusen, RPE abnormalities and atrophy.1
Consensus nomenclature for MNV
Neovascular or exudative—wet—AMD is diagnosed when there is macular neovascularization on multimodal imaging in the setting of drusen and RPE changes. Historically, neovascular AMD was defined as predominantly classic or occult based on angiographic patterns. Recent AMD consensus nomenclature2 has established use of the term macular neovascularization (MNV) and divided this into types 1, 2 and 3 MNV, primarily based on optical coherence tomography findings. In this classification, type 1 MNV corresponds to occult choroidal neovascularization while type 2 MNV corresponds to a classic CNV. Type 3 MNV corresponds to retinal angiomatous proliferation (RAP).
Characteristics of the three types of MNV in AMD are:
• Type 1 MNV involves the ingrowth of vessels initially from the choriocapillaris into the sub-RPE space.2 On fluorescein angiography, type 1 MNV depicts poorly defined regions of fluid leakage corresponding to a region of elevated RPE caused by the growth of these vessels.2 Angiographically, these lesions are typically classified as occult CNV and could present as a fibrovascular pigment epithelial detachment (PED) or late leakage of undetermined origin (Figure 2).
• Type 2 MNV grows from the choroid into the subretinal space. Consequently, hemorrhage or exudation often presents in the subretinal space and may compromise the neurosensory retina more severely.2 On FA, these lesions are typically classified as predominately classic CNV with a well-demarcated area of hyperfluorescence appearing early, expanding and ultimately obscuring the boundaries of the CNV from leakage (Figure 3).
![]() |
| Figure 1. Optical coherence tomography scan showing drusen (accumulation of deposits underneath the retinal pigment epithelium), a sign of dry age-related macular degeneration. |
• Type 3 MNV, also known as retinal angiomatous proliferation (RAP), differs from type 1 and 2 lesions as the neovascularization is thought to originate from within the retina itself and is often associated with intraretinal rather than subretinal fluid and hemorrhage. As it progresses, type 3 MNV forms a retinal-retinal anastomosis and invades the subretinal space with the development of a serous PED (Figure 4). Finally, a retinal-choroidal anastomosis occurs through the vertex of the PED with the development of CNV. Early type 3 lesions may present as a focal area of hyperfluorescence on FA. As the lesion progresses, a serous PED or CNV may appear on FA.
![]() |
| Figure 2. Two examples of type 1 macular neovascular membrane: A) Optical coherence tomography angiography en-face scan; and B) B-scan flow overlay showing subretinal pigment epithelium neovascular membranes. |
Nonexudative macular neovascularization
In 1973, John Sarks, MD, and colleagues reported a series of patients who had no clinical signs of neovascularization, but had type 1 MNV as revealed by histopathological analysis.3 More recently, with the advent of OCT angiography, many reports of patients with nonexudative, neovascular membranes have been published, suggesting the terms exudative and neovascular shouldn’t be used interchangeably.
![]() |
| Figure 3. Two examples of type 2 macular neovascular membranes. A) Optical coherence tomography angiography en-face scans; and B) B-scan flow overlays showing subretinal neovascular membranes. |
The term neovascular should refer to the presence of new vessels confirmed on OCTA, while exudative simply refers to the presence of fluid or hemorrhage as determined clinically or with OCT imaging (Figure 5). With the evolution of OCTA, the prevalence of subclinical nonexudative, neovascular lesions has been reported to range from 6 to 27 percent in fellow eyes of patients with nAMD, and serves as an important predictor of future exudation.4
The optimal management of patients with nonexudative MNV remains to be established.5 Some advocate educating these patients about warning symptoms and monitoring them closely for signs of exudation.
PEDs can occur in both non-neovascular and neovascular AMD. Four characteristic types of PEDs exist:
- drusenoid;
- serous;
- fibrovascular; and
- hemorrhagic.
A drusenoid PED is thought to be the result of coalescence of pre-existing soft drusen, whereas a serous PED represents a detachment of the RPE from Bruch’s membrane due to the accumulation of fluid.
![]() |
| Figure 4. An example of a type 3 macular neovascular membrane. A) Fundus photograph shows intraretinal hemorrhage and pseudodrusen. B) Corresponding optical coherence tomography B-scan shows serous pigment epithelial detachment, intraretinal fluid and subretinal hyperreflective density (asterisk). |
A vascularized PED occurs when abnormal vessels gain entry to the sub-RPE space through breaks in Bruch’s membrane. Signs of a vascularized PED include a notched or shallow irregular border to the PED, which can be associated with fluid, lipid exudate or hemorrhage. A shallow irregular RPE elevation (SIRE) on OCT should raise the suspicion of a vascularized PED or type 1 MNV. In some cases, banding can also be evident on OCT within a fibrovascular PED (Figure 6).
![]() |
An RPE tear is a risk particularly in a vascularized PED, with MNV at the margin of a large PED. When the MNV contracts, which can occur spontaneously or after treatment, the RPE can tear and roll up on itself, leading to an area of geographic atrophy. If this occurs in the center of the macula, the visual prognosis is poor. Sub-RPE hemorrhage, as in a hemorrhagic PED, will appear darker than subretinal hemorrhage.
Acquired vitelliform lesion
AVLs can also develop in AMD and can be mistaken for a drusenoid PED or even MNV. AVLs can be differentiated from drusenoid PEDs as the subretinal material accumulates above the RPE (Figure 7). AVLs can also be associated with optically empty spaces under the neurosensory retina, which also shouldn’t be mistaken for subretinal fluid from MNV in order to avoid unnecessary treatment. Unlike MNV, AVLs tend to be quite stationary over time. However, they can eventually regress, leading to GA and vision loss.
Fluid mimickers
![]() |
| Figure 6. A) Optical coherence tomography angiography B-scan with flow overlay (left) and en-face scan (right) show a vascularized pigment epithelial detachment. B) Shallow irregular retinal pigment epithelium elevation (SIRE). C) Fibrovascular PED with banding. |
Active exudation in AMD can present within the retina as intraretinal fluid in the form of cystoid macular edema, under the neurosensory retina in the subretinal space as subretinal fluid or under the RPE, leading to a PED. Vascular endothelial growth factor mediates IRF and SRF in nAMD, so it should respond to treatment with anti-VEGF injections. However, fluid in the setting of AMD can occur in other contexts.
For example, SRF associated with a PED has been well described in the setting of non-neovascular AMD in a few instances, such as a pocket of fluid along the edge of a PED, at the vertex of a PED or under the retina as it drapes over confluent PEDs (Figure 8).6 Unlike active exudate from a neovascular lesion, this fluid can be thought of as a transudate resulting from RPE dysfunction, due to relative ischemia of the RPE, as it is displaced from the underlying choriocapillaris.6,7 It’s important to identify this as nonexudative to avoid unnecessary treatment.
Also, SRF can sometimes be present as a result of RPE dysfunction without MNV in the setting of AMD, as confirmed on multimodal imaging. Some authors have suggested the term “nonexudative detachment of the neurosensory retina” (NEDNR) to describe the presence of SRF when there’s no evidence of neovascularization on multimodal imaging.8
![]() |
| Figure 7. Optical coherence tomography scan shows an acquired vitelliform lesion with accumulation of material above the retinal pigment epithelium (also associated epiretinal membrane). |
Patients can often be asymptomatic or minimally symptomatic from dry AMD changes. Care must be taken to not rush into treating these cases. SRF has been shown to not be as detrimental to the health of the overlying retina in cases where it’s not progressive, even in the presence of MNV.9,10 If MNV is excluded on multimodal imaging, these cases can be monitored closely for progressive vision loss or the development of MNV. The SRF tends to be stable and in some cases will resolve over time.
IRF is another location in which fluid in the setting of AMD can occur. IRF typically occurs from intraretinal neovascularization, or intraretinal migration of fluid originating from subretinal or sub-RPE neovascular lesions, with disruption of the outer retinal layers. This contrasts with macular edema in diabetic retinopathy or retinal vein occlusion, in which VEGF-mediated hyperpermeability of endothelial cells leads to IRF.11
![]() |
| Figure 8. Optical coherence tomography of a large pigment epithelial detachment associated with subretinal fluid at the edge (arrow) and vertex (asterisk) of the PED. |
However, IRF in the setting of AMD shouldn’t be mistaken for degenerative intraretinal cystoid lesions (ICLs), which can occur over RPE and outer retinal atrophy (RORA), and doesn’t respond to intravitreal anti-VEGF injections.12 ICLs often appear small and vertically oval in shape on OCT and are thought to be due to degeneration of Muller cells in the retina.
Similarly, outer retinal tubulation can be mistaken for IRF (Figure 9). Although outer retinal tubulation occurs in the setting of neovascular AMD, it develops as a result of damage to the underlying retina, is not exudative and generally remains stable over time even in patients receiving anti-VEGF therapy.13
![]() |
| Figure 9. Optical coherence tomography shows: A) degenerative intraretinal cystoid lesions overlying a disciform scar; and B) outer retinal tubulation. |
Exudation with IRF is typical in types 2 and 3 MNV. Type 1 MNV typically presents with fluid in the subretinal compartment. However, type 1 MNV with RORA may present with IRF in the absence of SRF (Figure 10). This has been described as a result of tight glial connections between the overlying outer retinal tissue and sub-RPE space, with intraretinal exudation through associated defects in the ELM, rather than the more common occurrence of SRF in type 1 lesions.14
Fluid: A differential diagnosis
The differential diagnosis of IRF should consider multiple classifications (Table below).
Exudation with IRF has also been reported in the setting of AMD in the absence of MNV on multimodal imaging. In this exudative form of non-neovascular AMD, IRF may suggest a form of preproliferative type 3 MNV unidentified on multimodal imaging. This has been described as increasingly elevated VEGF levels from a state of chronic retinal ischemia.15
These cases can also be monitored for progression if they’re asymptomatic and stable. However, if there is progressive accumulation of fluid or vision loss, these patients may respond to intravitreal anti-VEGF therapy despite the absence of MNV on multimodal imaging.
![]() |
| Figure 10. Optical coherence tomography scans of: A) incomplete retinal pigment epithelium and outer retinal atrophy (iRORA); and B) complete RPE and outer retinal atrophy (cRORA). |
Also included in the differential of fluid is a spectrum of intraretinal alterations that VEGF promotes, including excessive leakage from native retinal vessels, such as in macular telangiectasia, DME, retinal vein occlusions and perifoveal exudative vascular anomalous complex (PEVAC).
Perifoveal exudative vascular anomalous complex
PEVAC is a relatively newly described entity comprised of an isolated large perifoveal aneurysm in the absence of retinal vascular or inflammatory diseases in otherwise healthy individuals (Figure 11).16 The pathogenesis, course and best treatment for the condition isn’t certain,17 but it’s an important differential diagnosis to consider in patients with IRF.
![]() |
Polypoidal choroidal vasculopathy
PCV is a vascular disease of the choroid that was first described in the 1990s.18 PCV lesions contain polypoidal aneurysmal vascular dilations or terminal polyps with or without an associated type 1 branching vascular network (BVN).19 Clinically, PCV is associated with multiple PEDs, which may be serous or hemorrhagic.
An orange-red lesion may also appear in the choroid, indicating the presence of a polyp. Hard exudates are common, and hemorrhage may be found in all layers of the retina, including occasionally breaking through into the vitreous. Drusen is also conspicuously absent in patients with PCV.
![]() |
| Figure 11. Multimodal imaging of perifoveal exudative vascular anomalous complex (PEVAC) shows: A) an isolated aneurysm (arrow) temporal to the fovea; and B) confirmatory fundus fluorescein angiography. C) Optical coherence tomography shows the aneurysm with a hyperreflective wall and hyporeflective lumen. |
The gold standard for the diagnosis of PCV is indocyanine green angiography. Nonetheless, several studies have also shown that PCV can be diagnosed on enhanced-depth OCT imaging with a high degree of accuracy.20
The three major criteria for diagnosing PCV on OCT are:
- sub-RPE ring-like lesion (i.e., polyp);
- peaked PED; and
- complex RPE elevation on en face OCT.21,22
Other OCT features include:
- SRF rather than IRF;
- notched PED (a high PED with a low-lying PED indicating the presence of a BVN);
- double-layer sign (separation of the RPE from Bruch’s membrane); and
- pachychoroid.
PCV has been described as a variant of a type 1 MNV or it can occur as a standalone disease without signs of drusen and AMD. It’s now thought to be part of the pachychoroid spectrum, which includes central serous chorioretinopathy, pachychoroid epitheliopathy, pachychoroid CNV, peripapillary pachychoroid syndrome and focal choroidal excavation.
![]() |
Bottom line
Given the increase in life expectancy, the prevalence of AMD is predicted to increase substantially. It’s important for retina specialists to have an understanding of the classification of this complex disease, including all its subtypes, especially as the future promises new and exciting treatments for both neovascular and non-neovascular AMD as well as advances in imaging and information processing. RS
REFERENCES
1. Lindblad AS, Kassoff A, Kieval S, et al. The Age-Related Eye Disease Study (AREDS). Control Clin Trials. 1999;20:573-600.
2. Spaide RF, Jaffe GJ, Sarraf D, et al. Consensus nomenclature for reporting neovascular age-related macular degeneration data: Consensus on Neovascular Age-Related Macular Degeneration Nomenclature Study Group. Ophthalmology. 2019;127:616-636.
3. Sarks S, Cherepanoff S, Killingsworth M, Sarks J. Relationship of basal laminar deposit and membranous debris to the clinical presentation of early age-related macular degeneration. Invest Ophthalmol Vis Sci. 2007;48:968-977.
4. Laiginhas R, Yang J, Rosenfeld PJ. Non-exudative macular neovascularization – a systematic review of prevalence, natural history, and recent insights from oct angiography. Ophthalmol Retin. 2021;4:651-661.
5. Heier JS, Brown DM, Shah SP, et al. Intravitreal aflibercept injection vs sham as prophylaxis against conversion to exudative age-related macular degeneration in high-risk eyes. JAMA Ophthalmol. 2021;139:542.
6. Hilely A, Au A, Freund KB, et al. Non-neovascular age-related macular degeneration with subretinal fluid. Br J Ophthalmol. 2021;105:1415-1420.
7. Adijanto J, Banzon T, Jalickee S, Wang NS, Miller SS. CO2-induced ion and fluid transport in human retinal pigment epithelium. J Gen Physiol. 2009;133:603-622.
8. Lek JJ, Caruso E, Baglin EK, et al. Interpretation of subretinal fluid using OCT in intermediate age-related macular degeneration. Ophthalmol Retin. 2018;2:792-802.
9. Zarbin MA, Hill L, Maunz A, Gliem M, Stoilov I. Anti-VEGF-resistant subretinal fluid is associated with better vision and reduced risk of macular atrophy. Br J Ophthalmol. Published online May 26, 2021:doi:10.1136/bjophthalmol-2020-318688
10. Guymer RH, Markey CM, McAllister IL, et al. Tolerating subretinal fluid in neovascular age-related macular degeneration treated with ranibizumab using a treat-and-extend regimen: FLUID Study 24-month results. Ophthalmology. 2019;126:723-734.
11. Chung YR, Kim YH, Lee SY, Byeon HE, Lee K. Insights into the pathogenesis of cystoid macular edema: Leukostasis and related cytokines. Int J Ophthalmol. 2019;12:1202-1208.
12. Cohen SY, Dubois L, Nghiem-Buffet S, et al. Retinal pseudocysts in age-related geographic atrophy. Am J Ophthalmol. 2010;150:211-217.e1.
13. Iaculli C, Barone A, Scudieri M, Giovanna Palumbo M, Delle Noci N. Outer retinal tubulation. Retina. 2015;35:1979-1984.
14. Bacci T, Essilfie JO, Leong BCS, Freund KB. Exudative non-neovascular age-related macular degeneration. Graefe’s Arch Clin Exp Ophthalmol. 2021;259:1123-1134.
15. Bacci T, Essilfie JO, Leong BCS, Freund KB. Exudative non-neovascular age-related macular degeneration. Graefes Arch Clin Exp Ophthalmol. 2021;259:1123-1134.
16. Querques G, Kuhn D, Massamba N, Leveziel N, Querques L, Souied EH. Perifoveal exudative vascular anomalous complex. J Fr Ophtalmol. 2011;34:559.e1-559.e4. doi:10.1016/j.jfo.2011.03.002.
17. Mrejen S, Le HM, Nghiem-Buffet S, Tabary S, Quentel G, Cohen SY. Insights into perifoveal exudative vascular anomalous complex. Retina. 2020;40:80-86.
18. Kim JH, Chang YS, Kim JW, Lee TG, Kim HS. Diagnosis of Type 3 neovascularization based on optical coherence tomography images. Retina. 2016;36:1506-1515.
19. Ho CPS, Lai TYY. Current management strategy of polypoidal choroidal vasculopathy Diagnosis of PCV. Indian J Ophthalmol. 2018;66:1727-1735.
20. Chaikitmongkol V, Kong J, Khunsongkiet P, et al. Sensitivity and specificity of potential diagnostic features detected using fundus photography, optical coherence tomography, and fluorescein angiography for polypoidal choroidal vasculopathy. JAMA Ophthalmol. 2019;137:661-667.
21. Cheung CMG, Lai TYY, Ruamviboonsuk P, et al. Polypoidal choroidal vasculopathy: definition, pathogenesis, diagnosis, and management. Ophthalmology. 2018;125:708-724.
22. Cheung CMG, Lai TYY, Teo K, et al. Polypoidal choroidal vasculopathy: consensus nomenclature and non–indocyanine green angiograph diagnostic criteria from the Asia-Pacific Ocular Imaging Society PCV Workgroup. Ophthalmology. 2021;128:443-452.